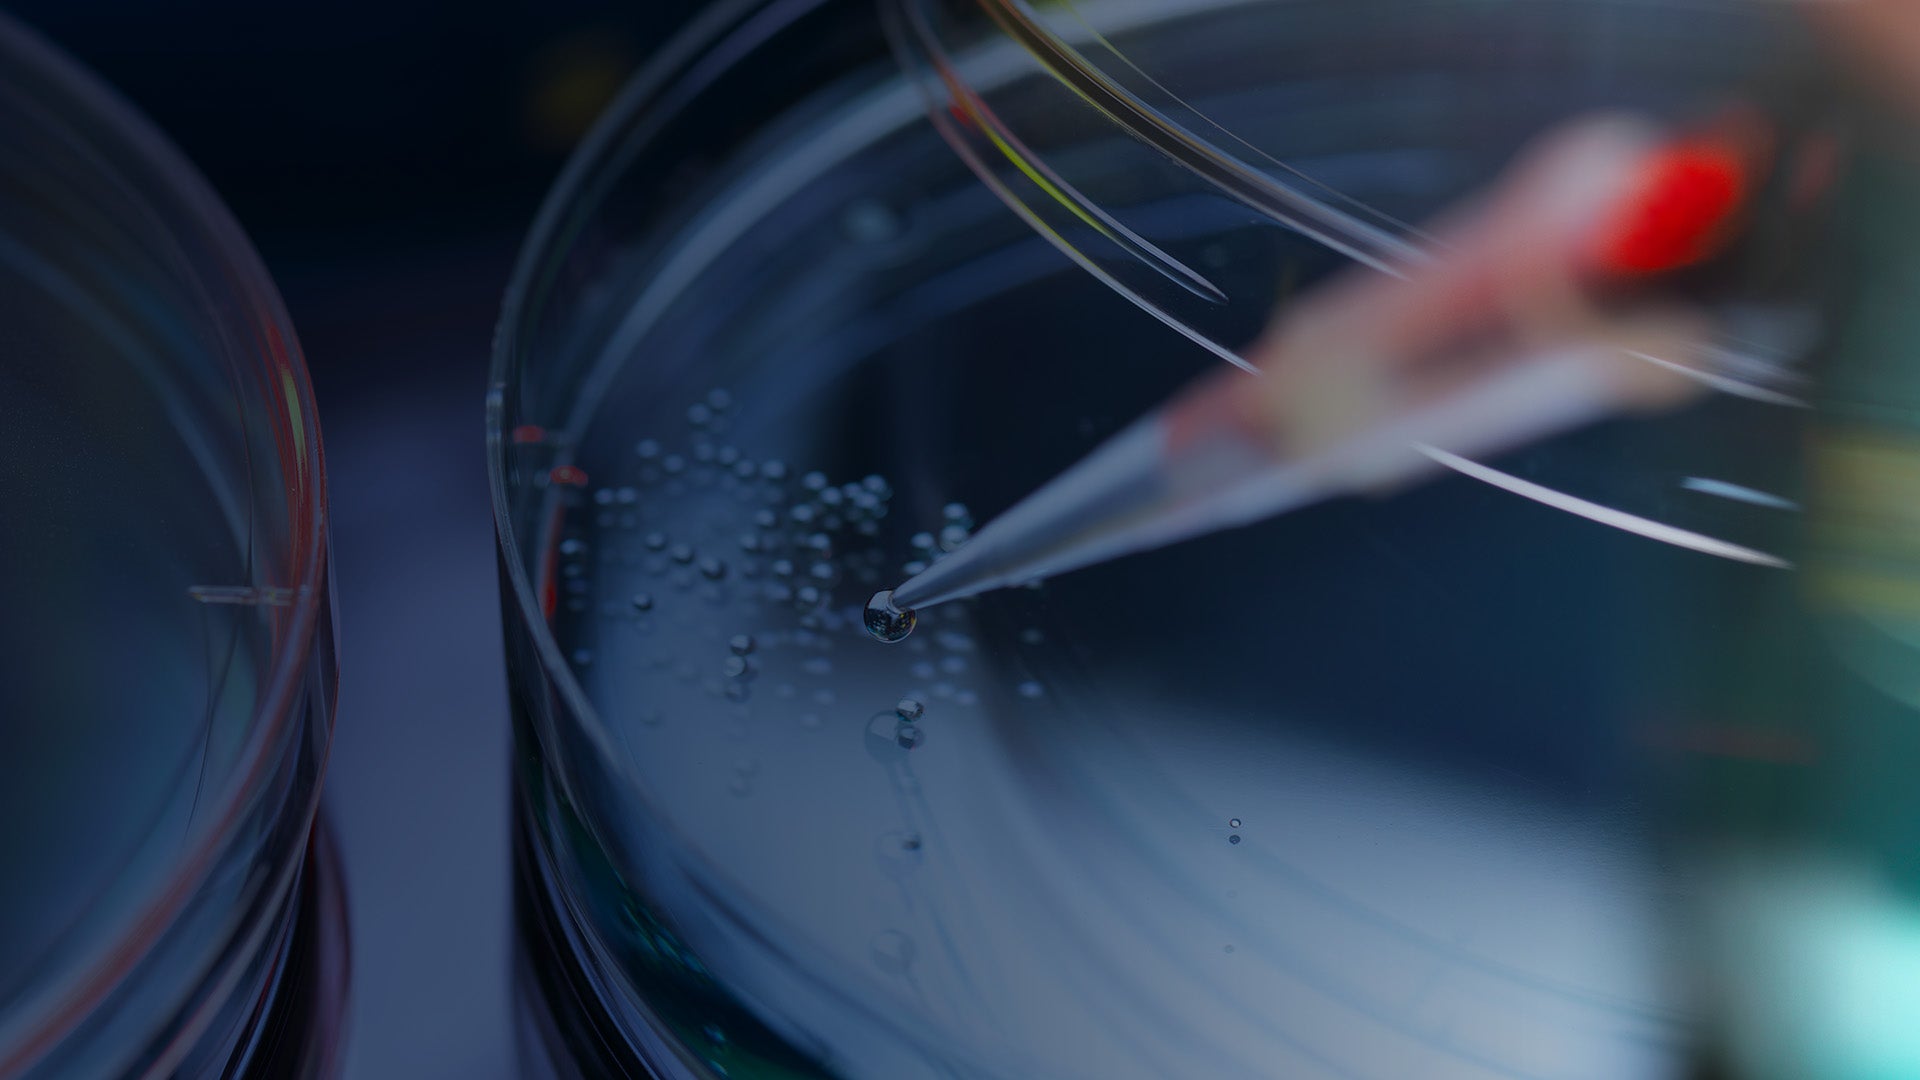
Close-up of a pipette dispensing liquid into a petri dish with droplets, representing biomedical research and health sciences.

Troutman Pepper Locke Represents CortiCare in Acquisition of Integris Neuro
INDUSTRY
Health Care + Life Sciences
Our professionals collaborate to solve complex legal challenges confronting clients, offering a full suite of corporate, intellectual property, regulatory, and litigation services.
Solving Complex Legal Challenges
Now, more than ever, health care and life sciences are vital to global economic and social health.
Experienced, industry-savvy legal counsel enables clients to bring value quickly to the market and to their stakeholders. Our health care and life sciences practice was founded more than 60 years ago, and encompasses the entire spectrum of health care and life sciences companies.
Our 350+ attorneys and professionals collaborate across disciplines to solve complex legal challenges confronting our clients, offering a full suite of corporate, intellectual property, regulatory, and litigation services.
Few law firms have a comparable health care and life sciences practice. Increasingly, issues in one sector impact participants across the health sciences ecosystem and supply chain, from the R&D lab to the delivery of patient care. We draw on our deep industry knowledge to provide the precise, holistic advice and guidance our clients need throughout their business cycles.
Health care + Life Sciences achievements
Our highest goal? Achieving yours.

Find your professional

This just in
Speaking Engagements
2026 ACI Women Leaders in Life Sciences Law
July 29 – 30, 2026
Seaport Hotel Boston
1 Seaport Ln, Boston, MA 02210
Webinars
Academic Innovation to Market Reality: Best Practices for University Spin-Offs
July 22, 2026 | 12:00 PM – 1:00 PM ET
Virtual
Firm News
Troutman Pepper Locke Wins M&A Practice of the Year, Laurenlee Dominguez Takes Most Promising Newcomer at 2026 Pennsylvania Legal Awards
June 12, 2026
Sponsored Events
Texas Tech MDL Judicial Summit 2026
June 3 – 6, 2026
The Ritz Carlton
1881 Curtis Street, Denver, CO 80202
PODCAST
The Good Bot: AI, Health Care, and the Law
This comprehensive series delves into the intersection of artificial intelligence (AI), health care, and the impact of current and new laws on the advancement of technology in health care services.